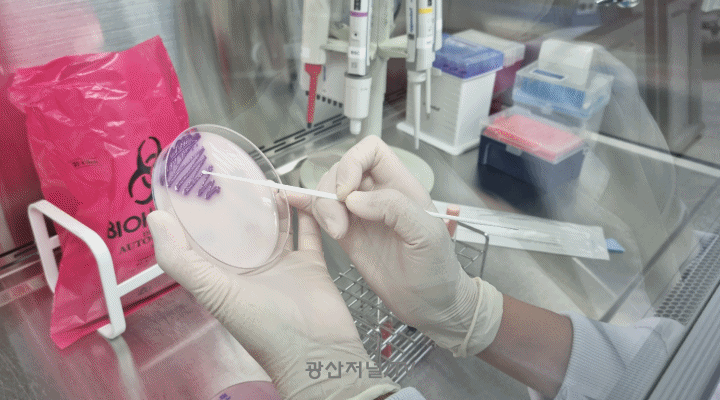

[종합] 광주고려인마을, 국내외 언론보도 누적횟수 1만1천 건 돌파 |2023. 08.18 [종합] 광주고려인마을, 국내외 언론보도 누적횟수 1만1천 건 돌파 |2023. 08.18
[광산저널] 역사마을1번지 광주고려인마을과 관련된 국내외 언론사가 보도한 뉴스가 1만1천 건이 넘어섰다.
18일 고려인마을에 따르면, 지난 2013년 홈페이지 오픈 후 10년 만에 보도자료 기록 누적 횟수가 11,291건에 이르고 있어, 고… |
|
 [종합] 1전비, 고창 동호해수욕장 환경미화 실시 |2023. 08.17 [종합] 1전비, 고창 동호해수욕장 환경미화 실시 |2023. 08.17
[광산저널] 공군 제1전투비행단(이하 ‘1전비’)은 8월 17일(목) 대민봉사의 일환으로 미여도 사격장 인근 고창군 해리면 동호해수욕장을 방문해 환경미화활동을 실시했다.
고창 동호해수욕장 인근은 국방부의 항공기 소음피해보상 기… |
|
 [종합] 광산구, 제15회 교통·사회 안전대축전 종합대상 ‘2관왕’ |2023. 08.17 [종합] 광산구, 제15회 교통·사회 안전대축전 종합대상 ‘2관왕’ |2023. 08.17
[광산저널] 광주 광산구(구청장 박병규)는 17일 ‘제15회 교통‧사회 안전대축전’ 전 부문에서 종합대상(광주광역시장상)을 수상했다고 밝혔다.
광남일보 등이 주최‧주관하고, 국토교통부, 광주시와 전라남도 등이 후원하… |
|
 [종합] 광산구의회 ‘광산형 통합돌봄’ 의원연구단체, 정책 세미나 개최 |2023. 08.17 [종합] 광산구의회 ‘광산형 통합돌봄’ 의원연구단체, 정책 세미나 개최 |2023. 08.17
[광산저널] 광산구의회(의장 김태완) 의원연구단체인 ‘광산형 통합돌봄 의원 연구모임(대표의원 윤혜영)’이 17일 광산형 통합돌봄 정책 마련을 위한 전문가 초청 세미나를 열었다.
이번 세미나는 지역사회의 통합돌봄 필요성에 공감… |
|
 [종합] 시립병원 파업에 따른 광주광역시 입장문 |2023. 08.17 [종합] 시립병원 파업에 따른 광주광역시 입장문 |2023. 08.17
[광산저널] 시립병원의 장기 파업으로 시민 여러분께 불편을 끼쳐 안타깝게 생각합니다.
시는 전문성 강화를 위해 시립병원을 전문 의료법인이 경영을 책임지는 민간위탁 방식으로 운영해왔습니다. 이에 경영 등에 개입하는 데에는 한… |
|
 [종합] 삼도동 주민자치회 발대 |2023. 08.17 [종합] 삼도동 주민자치회 발대 |2023. 08.17
[광산저널] 광주 광산구 삼도동 주민자치회(회장 오연교)가 17일 발대식을 열고 힘찬 출발을 알렸다.
발대식은 주민자치회 설립 추진 과정 공유, 위촉장 수여, 사무국 현판 제막식 순으로 진행됐다.
삼도동 주민자치회는 광산구 21… |
|
 [이현선 광산의 문화유산] 민족문예운동가 용아 박용철 ⑥ |2023. 08.17 [이현선 광산의 문화유산] 민족문예운동가 용아 박용철 ⑥ |2023. 08.17
[광산저널] 용아가 병실에서 휴지조각에 꾹꾹 눌러 쓴 마지막 시, 네 편 ⟨해후⟩⟨안가는 시계⟩⟨인형⟩중의 한편이다.
그는 자신이, 아무도 그를 위해 ’베아트리체의 시‘를 써주는 사람이 없… |
|
 [종합] 호남대 건축학과, ‘제 6회 광주건축대전 공모전’ 특선 영예 |2023. 08.17 [종합] 호남대 건축학과, ‘제 6회 광주건축대전 공모전’ 특선 영예 |2023. 08.17
[광산저널] 호남대학교 건축학과(학과장 박지훈)의 진수림 학생(4학년)이 전국 규모의 건축설계 분야 공모전인 ‘제 6회 광주건축대전 공모전’에서 특선을 차지하는 영예를 안았다.
광주건축대전은 (사)한국건축가협회 광주전남건축… |
|
 [종합] ‘살인예고글은 범죄행위’인식 확산을 위한 이상동기범죄 예방교육 실시 |2023. 08.17 [종합] ‘살인예고글은 범죄행위’인식 확산을 위한 이상동기범죄 예방교육 실시 |2023. 08.17
[광산저널] 광주 광산경찰서(경무관 강일원)는 지난 8.16 광산구 월계동 소재 첨단고(교장 김형태)에서 2학기 개학을 맞아 ‘살인예고글은 범죄행위’인식 확산을 위한 예방교육을 실시했다.
살인예고글 전국적 게시 유포로, 중요밀집… |
|
 [종합] 무더위 속 세균성 장염·수족구병 증가 |2023. 08.17 [종합] 무더위 속 세균성 장염·수족구병 증가 |2023. 08.17
[광산저널] 광주광역시보건환경연구원은 17일 무더위가 기승을 부리면서 세균성 장염, 수족구병 등 여름철 감염성질환이 증가함에 따라 개인 위생과 음식물 관리에 각별히 주의해줄 것을 당부했다.
광주보건환경연구원은 질병관리청 … |
|
 [종합] 재난상황 최일선 진두지휘 “안심하세요” |2023. 08.17 [종합] 재난상황 최일선 진두지휘 “안심하세요” |2023. 08.17
[광산저널] 전에 없는 날씨와의 전쟁이다. 극한 폭우를 동반한 긴 장마가 지나고, 유례없는 폭염, 그리고 태풍까지….
극한 자연과 싸우는 사람들이 있다. 바로 광주광역시 자연재난과 자연재난대응팀(최인홍 팀장, 임재원·김성환·… |
|
 [종합] 광산구 마을복지건강계획 ‘찾아가는 자문단’ 운영 |2023. 08.17 [종합] 광산구 마을복지건강계획 ‘찾아가는 자문단’ 운영 |2023. 08.17
[광산저널] 광주 광산구(구청장 박병규)는 내년도 마을복지건강계획 수립에 도움을 주기 위해 이달 말까지 ‘찾아가는 자문단’을 운영한다고 밝혔다.
광산구 21개 동은 주민이 중심이 돼 마을 특색, 시대변화 등을 반영한 의제와 해결… |
|
 [종합] 정원에 담긴 차와 사교 문화 |2023. 08.17 [종합] 정원에 담긴 차와 사교 문화 |2023. 08.17
[광산저널] 광주 광산구(구청장 박병규) 장덕도서관이 ‘길 위의 인문학’으로 여는 ‘정원에 담긴 차와 사교 문화’ 인문학 강연 참여자를 모집한다.
‘길 위의 인문학’은 문화체육관광부가 주최하고 한국도서관협회가 주관하는 공모… |
|
| [칼럼/기고] [칼럼/기고] 국민연금 조기수령 받는 경우가 증가하는 이유 |2023. 08.17
[광산저널] 1969년 이후 출생자는 기본적으로 국민연금을 65세부터 수령할 수 있는데, 원하는 경우 60세부터 최대 5녀는 당겨 받을 수 있다. 국민연금을 예정보다 일찍 당겨 받고 있는 사람 수가 80만명을 넘었다.
국민연금을 당겨 받… |
|
 [종합] 광주고려인마을, ‘항일무장투쟁의 별’ 김경천 장군 세미나 개최 |2023. 08.17 [종합] 광주고려인마을, ‘항일무장투쟁의 별’ 김경천 장군 세미나 개최 |2023. 08.17
[광산저널] 광주고려인마을은 일제 강점기 러시아 시베리아에서 항일 무장투쟁을 벌여 수많은 전과를 올렸던 김경천 장군의 항일애국정신을 계승하기 위한 ’특별전 및 기념세미나’ 를 개최한다.
고려인마을은 지난 15일 광복절 제78… |
|
 [종합] 광주고려인마을, 국내외 언론보도 누적횟수 1만1천 건 돌파 |2023. 08.18
[종합] 광주고려인마을, 국내외 언론보도 누적횟수 1만1천 건 돌파 |2023. 08.18
 [종합] 1전비, 고창 동호해수욕장 환경미화 실시 |2023. 08.17
[종합] 1전비, 고창 동호해수욕장 환경미화 실시 |2023. 08.17
 [종합] 광산구, 제15회 교통·사회 안전대축전 종합대상 ‘2관왕’ |2023. 08.17
[종합] 광산구, 제15회 교통·사회 안전대축전 종합대상 ‘2관왕’ |2023. 08.17
 [종합] 광산구의회 ‘광산형 통합돌봄’ 의원연구단체, 정책 세미나 개최 |2023. 08.17
[종합] 광산구의회 ‘광산형 통합돌봄’ 의원연구단체, 정책 세미나 개최 |2023. 08.17
 [종합] 시립병원 파업에 따른 광주광역시 입장문 |2023. 08.17
[종합] 시립병원 파업에 따른 광주광역시 입장문 |2023. 08.17
 [종합] 삼도동 주민자치회 발대 |2023. 08.17
[종합] 삼도동 주민자치회 발대 |2023. 08.17
 [이현선 광산의 문화유산] 민족문예운동가 용아 박용철 ⑥ |2023. 08.17
[이현선 광산의 문화유산] 민족문예운동가 용아 박용철 ⑥ |2023. 08.17
 [종합] 호남대 건축학과, ‘제 6회 광주건축대전 공모전’ 특선 영예 |2023. 08.17
[종합] 호남대 건축학과, ‘제 6회 광주건축대전 공모전’ 특선 영예 |2023. 08.17
 [종합] ‘살인예고글은 범죄행위’인식 확산을 위한 이상동기범죄 예방교육 실시 |2023. 08.17
[종합] ‘살인예고글은 범죄행위’인식 확산을 위한 이상동기범죄 예방교육 실시 |2023. 08.17
[종합] 무더위 속 세균성 장염·수족구병 증가 |2023. 08.17
[종합] 무더위 속 세균성 장염·수족구병 증가 |2023. 08.17
 [종합] 재난상황 최일선 진두지휘 “안심하세요” |2023. 08.17
[종합] 재난상황 최일선 진두지휘 “안심하세요” |2023. 08.17
 [종합] 광산구 마을복지건강계획 ‘찾아가는 자문단’ 운영 |2023. 08.17
[종합] 광산구 마을복지건강계획 ‘찾아가는 자문단’ 운영 |2023. 08.17
 [종합] 정원에 담긴 차와 사교 문화 |2023. 08.17
[종합] 정원에 담긴 차와 사교 문화 |2023. 08.17
 [종합] 광주고려인마을, ‘항일무장투쟁의 별’ 김경천 장군 세미나 개최 |2023. 08.17
[종합] 광주고려인마을, ‘항일무장투쟁의 별’ 김경천 장군 세미나 개최 |2023. 08.17
 2026.03.25(수) 11:04
2026.03.25(수) 11:04









